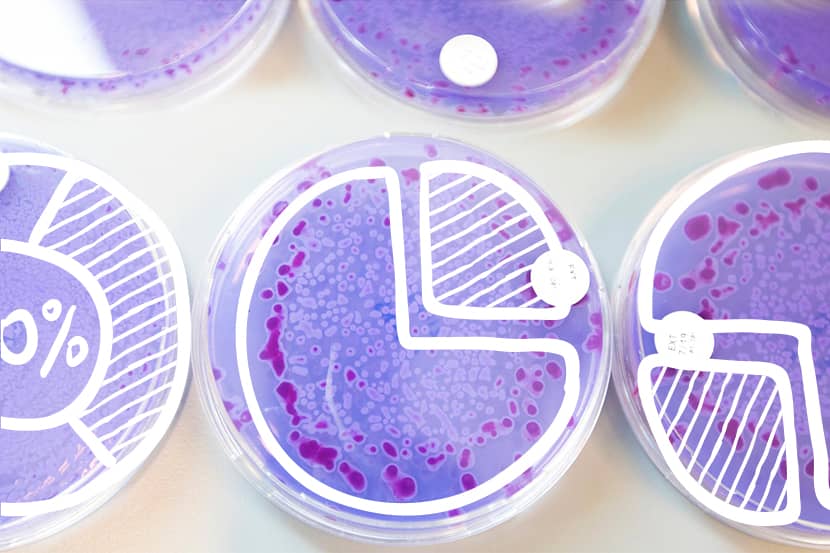

Bekijk per beleidsterrein van het ministerie van Onderwijs, Cultuur en Wetenschap de beschikbare cijferinformatie; kerncijfers over het stelsel, cijferinformatie over specifieke thema's en onderwerpen, Nederland internationaal vergeleken én andere beschikbare databronnen en monitors. Bij 'begroten en verantwoorden' vindt u begrotingsinformatie en de beleidsindicatoren (niet-financiele-informatie) uit de begroting van OCW.
Uitgelichte thema's
Bekijk ook
Nieuws
Referentieraming 2026
De Referentieraming presenteert de verwachte ontwikkeling van het aantal leerlingen en studenten voor het bekostigd onderwijs ...
Lees verderTrendrapportage arbeidsmarkt leraren 2025: actuele gegevens beschikbaar
Gegevens rond de arbeidsmarkt voor leraren in het primair onderwijs (po), voortgezet onderwijs (vo) en middelbaar ...
Lees verderCijfers over de aansluiting van onderwijs op de arbeidsmarkt in 2023 en 2024 bekend
Er zijn nieuwe cijfers beschikbaar over de aansluiting van onderwijs op de arbeidsmarkt. Deze cijfers geven inzicht in de positie ...
Lees verder